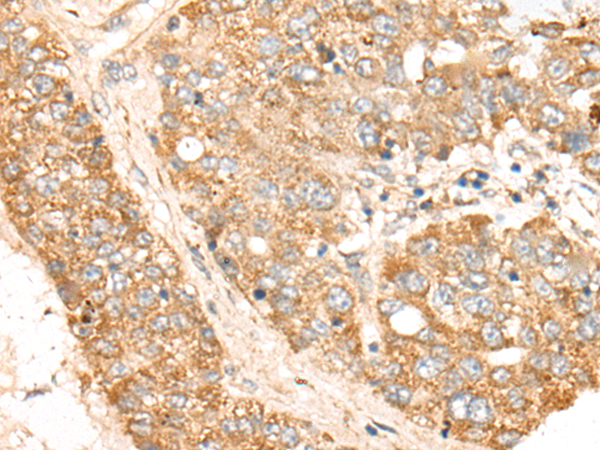
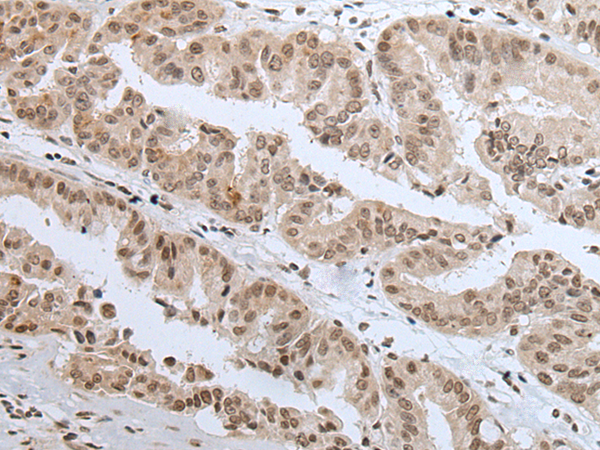

-
分类: 科研抗体货号: P09260别名: CR; CRGF; CRIPTO应用: IHC反应种属: Human
-
分类: 科研抗体货号: P09259别名:应用: WB,IHC反应种属: Human
-
分类: 科研抗体货号: P09275别名: WDF1; FENS-1; ZFYVE17应用: WB,IHC反应种属: Human, Mouse
-
分类: 科研抗体货号: P09258别名:应用: WB反应种属: Human, Mouse, Rat
-
分类: 科研抗体货号: P09263别名: FKSG3应用: IHC反应种属: Human, Mouse
-
分类: 科研抗体货号: P09273别名: WBP5; WEX6应用: IHC反应种属: Human
-
分类: 科研抗体货号: P09257别名: H3/A; H3FA; HIST1H3A应用: WB,IHC反应种属: Human, Mouse
-
分类: 科研抗体货号: P09262别名: TAR; Y14; RBM8; ZNRP; RBM8B; ZRNP1; BOV-1A; BOV-1B; BOV-1C; MDS014; DEL1q21.1; C1DELq21.1应用: WB,IHC反应种属: Human, Mouse, Rat
-
分类: 科研抗体货号: P09271别名: WAVE; SCAR1; WAVE1; NEDALVS应用: WB,IHC反应种属: Human, Mouse, Rat
-
分类: 科研抗体货号: P09256别名: ATAC1应用: IHC反应种属: Human, Mouse

鄂公网安备42018502007531号
鄂公网安备42018502007531号

